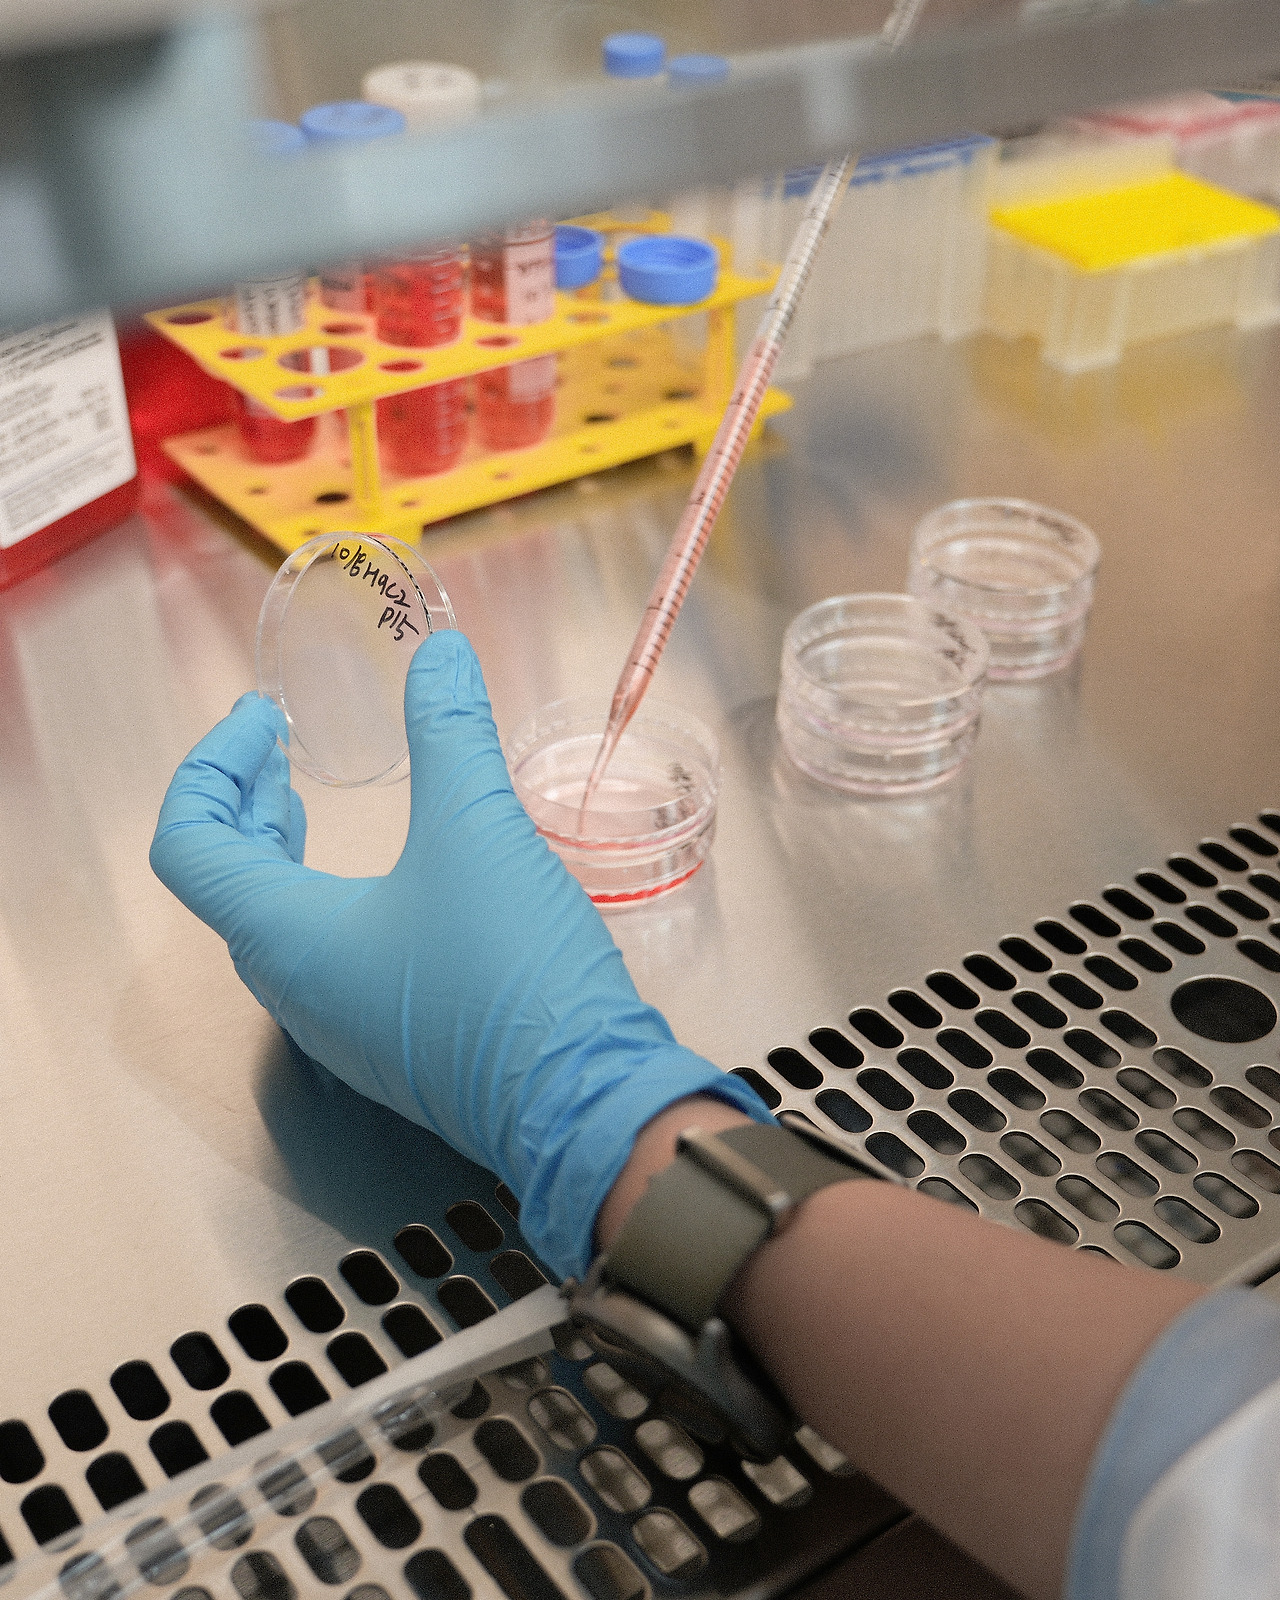
1024_연구전담부서-3.jpg

오니스트 연구전담부서를 소개합니다
오니스트가 고유의 전문성을 갖춰나가는 방식
오니스트가 최근에 연구전담부서를 새로 개설했어요. 자체 검증 시스템을 도입하며 더욱 신뢰도 높은 제품을 만들기 위해서인데요. 오니스트를 사랑해주시는 분들이 궁금하실 점들을 모아, 제품 개발 연구원 Sophie에게 답변을 부탁드렸어요.

Q. 오니스트는 왜 연구전담부서를 개설했나요?
오니스트는 제품 개발의 최우선 가치를 신뢰할 수 있는 원료 선정으로 두고 있어요. 그저 유명해서, 흔히 사용된다는 이유로 원료를 선정하는 건 있을 수 없는 일이죠.
현재 오니스트 제품에 사용되는 원료는 모두 순도와 효능이 검증된, 클린원칙을 지킨 원료들이라고 자부해요. 좋은 원료, 믿을 수 있는 원료를 사용하고 이를 투명하게 공개하는 것. 그게 많은 분들이 오니스트 제품을 사랑해주시는 이유라고 생각하고요.
오니스트 연구전담부서는 이러한 원칙을 더욱 높은 기준으로 지키기 위해 개설되었어요. 선별한 원료들의 최적 배합을 찾고, 제품의 효능을 자체 검증함으로써 오니스트만의 전문성을 더욱 높일 거예요. 그 시작을 함께할 수 있어 많은 기대가 됩니다.

Q. 연구전담부서는 어떤 일을 하나요?
오니스트 연구전담부서는 제품에 활용하는 원료의 효능을 직접 확인하고, 원료의 성분이 실제 세포에 어떤 유효성을 보이는지 검증하려 해요. 이러한 검증을 통해 신제품 개발 및 기존 제품 퀄리티 관리를 진행할 계획입니다.


1. 신제품 개발
오니스트 연구전담부서의 가장 큰 역할은 신제품 개발의 과학적 신뢰도를 더욱 높이는 것이에요. 개발 과정에서 선별된 모든 원료들의 독성 및 효능 평가를 자체적으로 실시하고, 더욱 꼼꼼히 검증하려 해요.
대부분의 좋은 원료는 전 세계의 많은 그룹을 통해 효능과 작용 기전이 보고되었어요. 그렇지만 오니스트가 만들 제품에 단 하나의 원료만 들어가는 것은 아니에요. 아무리 많은 연구가 보고된 원료를 사용한다고 해도, 함께 배합하여 섭취했을 때 예상치 못한 효과가 발생할 가능성이 있어요. 독성이 생기거나, 반대로 예상보다 뛰어난 시너지 효과를 보일 수 있죠.
오니스트는 앞으로 더욱 다양한 원료를 활용한 제품을 만들 계획이에요. 그래서 이러한 연구에 매진할 전문 팀이 필요하다고 판단했어요. 작은 가능성도 놓치지 않고, 더욱 체계적인 자체 검증 시스템을 도입해 제품에 사용하려는 모든 원료들의 효능을 직접 확인할 예정이예요. 많은 분들이 믿고 드실 수 있는 제품을 만들기 위해 각 원료의 함량 검증부터 독성 평가, 효능 평가를 통해 시너지 높고 효율적인 배합을 찾아갈 거예요.
2. 기존 제품 퀄리티 관리
오니스트는 영양제 시장의 고질적인 문제였던 정보 비대칭성을 해결하는 브랜드예요. 신뢰도 높은 원료와 배합으로 제품을 만들고, 이를 투명하게 공개해 고객분들이 필요한 제품을 쉽게 선택하도록 돕고 있죠. 자극적인 광고 없이도 많은 분들의 사랑을 받는 건 이런 이유 때문이라고 생각해요.
오니스트 연구전담부서는 우리 원료와 제품에 대한 믿을 수 있는 정보를 더 자세히 전해드리고 싶어요. 지금처럼 꼼꼼한 사전 검증을 통해 신뢰할 수 있는 원료를 선정하는 건 물론이고, 직접 검증한 과학적 데이터로 실제 효능에 대한 신뢰도 높은 정보를 제공할게요.
예를 들어 ‘유효 성분 지표가 이만큼 들어가 있으니 좋다!’ 는 점을 왜, 어떻게 좋은지 풀어내고 싶어요. 유효 성분의 함량이 높아도 체내 유효성이 낮다면 섭취하는 의미가 적지 않을까요? 해당 성분이 실제 세포에 어떤 유효성을 보이는지 검증함으로써, 섭취 후 체내 유효성이 높은 원료인지를 살펴볼 수 있겠죠.
지금은 가수분해피쉬콜라겐 내 GPH 성분 분석, 플라보노이드 실제 함량 분석 등 많은 고객분들이 궁금해하시는 것들을 우선적으로 연구하고 있어요. 조만간 전해드릴 연구 결과도 기대해 주세요.
Q. 앞으로 연구전담부서가 나아갈 방향이 궁금해요.
신뢰도 높은 원료만 사용하고, 믿을 수 있는 제품을 만들어 온 오니스트. 우리가 나아가야 할 방향은 보다 깊이 있는 제품 개발 연구라고 생각해요.
좋은 원료 선정과 효능 검증, 제품 개발에서 아무리 말해도 부족할 만큼 중요한 항목이죠. 하지만 고객 입장에서 얻을 수 있는 정보에는 한계가 있어요. 연구원이기 이전에 건강기능식품을 챙겨 왔던 고객이기에, 저 역시 제한된 정보 속에서 많은 답답함을 느꼈었고요.
믿고 선택할 수 있는 제품의 가치를 잘 알기에, 제품 개발에 있어 원료 업체의 자료나 논문에 보고된 정보에 만족하지 않고 새로운 정보를 발굴하고 검증할 거예요. 지금도 새롭게 개발할 제품들의 효과를 높일 연구가 한창 진행 중이랍니다.
원료 하나하나 깊이 연구하고 꼼꼼히 검증하여 오니스트만의 제품 개발 영역을 더욱 넓혀가고 싶어요. 왜 오니스트여야만 하는지, 과학적 데이터를 기반으로 증명하고자 해요. 오니스트만의 유일무이한 제품 개발을 위해, 차별성 있고 깊이 있는 연구를 위해. 오니스트 연구전담부서가 직접! 발로 뛰겠습니다.